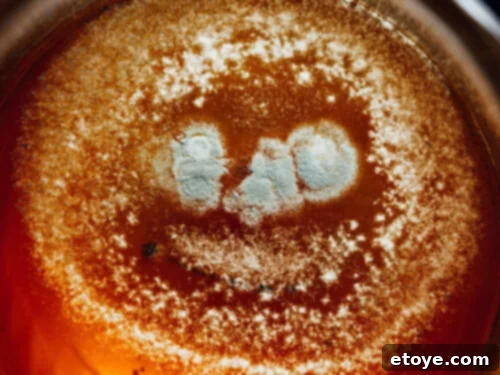
Shelf Life of Refrigerated Tea 5 Mold growing in tea

Ever stumbled upon a forgotten pitcher of iced tea tucked away at the back of your fridge? You’re certainly not alone! As devoted tea enthusiasts, it’s common to brew a larger batch than we can finish in one sitting, especially when preparing refreshing cold teas to combat the summer heat. Whether it’s a delicate white tea or a robust black tea, mastering the art of proper storage is key to preserving its freshness and exquisite flavor.
But fear not, fellow tea lovers! We’re here to guide you through the best practices for storing your beloved brew, ensuring every sip is as delightful as the first. Let’s delve into the world of tea storage and unlock the secrets to keeping your tea in its prime.

How Long Does Brewed Tea Stay Fresh in the Fridge?
For those eager for a quick answer, here’s the golden rule: generally, brewed tea maintains its freshness and peak flavor in the refrigerator for approximately 3 to 5 days. However, with optimal storage conditions—specifically, using an airtight container and keeping it well away from strong-smelling foods—you might even extend its pristine quality for up to a full week before any noticeable alteration in taste occurs. It’s important to remember that this timeframe can fluctuate based on several variables, including the specific type of tea, its preparation method, and any added ingredients. For instance, a sweet tea infused with sugar will have a different shelf life than a plain cold brew tea.
Storing your tea in the fridge is an excellent strategy to prolong its life, particularly during warmer months when ambient temperatures can accelerate spoilage. If you’re eyeing that pitcher of iced tea in your fridge and questioning its drinkability, consider the brew date and how it has been stored. If it falls within this ideal window of a few days and still emits a fresh aroma reminiscent of the day it was brewed, you’re likely safe to enjoy it. However, if you’ve surpassed the week mark or detect any unusual changes in flavor, color, or smell, it’s always prudent to err on the side of caution and prepare a fresh batch. After all, nothing quite compares to the invigorating taste of freshly brewed tea.

Key Factors Influencing Tea’s Shelf Life in Refrigerated Storage
Understanding the elements that affect your tea’s longevity in the fridge is crucial for maintaining its quality and ensuring a safe, enjoyable drinking experience. Here’s a closer look:
The Type of Tea
From the delicate nuances of white tea to the bold character of black tea, not all teas are created equal, and their shelf lives vary significantly. This difference primarily stems from their unique processing methods and inherent ingredient compositions. Teas with a higher moisture content, typically those that undergo less oxidation like green tea or certain herbal infusions, tend to be more susceptible to the growth of mold and bacteria. Their less-processed state means they retain more natural compounds that can break down quickly. In contrast, fully oxidized teas such as black tea often boast a slightly extended shelf life due to their robust structure, which is a result of extensive enzymatic reactions during processing. Oolong tea, with its partial oxidation, falls somewhere in between.
The Way It’s Prepared
Your brewing method plays a pivotal role in determining how long your tea remains fresh. Cold brew tea, made by steeping tea leaves in cold water for an extended period, naturally creates an environment less conducive to rapid bacterial growth due to the absence of heat. This slow extraction process limits the release of certain compounds that can accelerate spoilage. Conversely, sun tea, a method involving placing tea in direct sunlight to brew, carries a higher risk. The gradual increase in temperature during sun brewing can create a “danger zone” (temperatures between 40°F and 140°F or 4°C and 60°C) where bacteria, including harmful pathogens, can multiply rapidly if the tea is not immediately refrigerated and cooled quickly after brewing. Hot-brewed tea that is left to cool to room temperature before refrigeration also requires careful handling; the longer it sits at room temperature, the greater the chance for bacterial growth.
How It’s Stored
The secret mantra for maximizing your tea’s fridge life is simple yet profoundly effective: always use airtight containers, keep it shielded from direct sunlight, and store it in a cool, consistent environment within your refrigerator. Oxygen, light, and heat are flavor’s formidable adversaries. By sealing your tea in an airtight container, you establish a protective barrier against oxygen, which can hasten oxidation and diminish flavor, and also prevent your tea from absorbing the myriad odors present in your fridge—a common complaint among tea drinkers. Imagine your delicate green tea tasting faintly of last night’s garlic pasta! Furthermore, storing it away from light and fluctuating temperatures helps preserve the nuanced flavor profiles and beneficial compounds that make your tea so enjoyable.
What You Add To It
While a splash of milk, a dollop of honey, or a squeeze of fruit juice can elevate your tea-drinking experience, these additions significantly impact how long your brew stays fresh in the fridge. Perishable ingredients like milk and fruit juices introduce their own bacteria and natural enzymes, accelerating spoilage. They create a more nutrient-rich environment, fostering faster bacterial growth. Sweeteners, such as sugar or honey, can also alter the storage dynamics by providing an attractive food source for certain microorganisms, potentially leading to fermentation or spoilage. For the longest possible shelf life, plain, unsweetened tea is your best bet. Consider adding these delightful extras just before you’re ready to enjoy your tea, rather than incorporating them into the batch you intend to store.

Essential Tips for Storing Brewed Tea in Your Fridge
To ensure your tea remains delicious and safe to drink, follow these practical storage tips:
Cool It Down Quickly
One of the most critical rules for preserving the quality and safety of brewed tea, especially hot-brewed varieties, is to cool it rapidly. This isn’t just about maintaining delicate flavors; it’s a fundamental food safety principle. Bacteria thrive in what’s known as the “danger zone,” temperatures between 40°F and 140°F (4°C and 60°C). By swiftly reducing the temperature of your freshly brewed tea, you significantly minimize the time it spends in this zone, thus inhibiting bacterial growth. A great method for rapid cooling is to place your hot tea container in an ice bath. Once it reaches room temperature (which should be as quickly as possible, ideally within an hour or two), don’t leave it on the counter; transfer it to the refrigerator immediately. This quick transition locks in freshness and helps retain the tea’s beneficial properties.
Utilize Airtight Containers
To preserve your tea’s pristine taste and aroma, invest in high-quality airtight containers. Mason jars with tight-fitting lids, glass pitchers with seals, or food-grade plastic containers are excellent choices. These containers create an impenetrable barrier that prevents two key issues: oxidation, which degrades flavor, and the absorption of odors from other foods in your fridge. Think of how quickly bread can absorb onion smells! Your fridge, while cool, isn’t completely free of airborne food particles and aromas. An airtight seal acts as your tea’s personal protective bubble, shielding it from external contaminants and maintaining its original flavor profile. Furthermore, glass and opaque containers offer an additional layer of protection from any ambient light within your refrigerator.
Label Your Brews
In the hustle and bustle of daily life, it’s easy to lose track of when you brewed a batch of tea. Eliminate any guesswork and potential food safety concerns by getting into the simple habit of labeling your containers with the date your tea was made. A small piece of masking tape and a marker are all you need. This straightforward practice allows you to quickly assess the freshness of your tea, ensuring you consume it within its optimal window. With clear dates, you can confidently enjoy your tea at its peak freshness, free from any lingering doubts about its age.
Recognizing Signs of Spoiled Tea
Knowing when to part ways with your brewed tea is paramount for both food safety and enjoying a pleasant beverage. Here are the definitive indicators that your tea is past its prime and should be discarded:
- Off-Smell: Your nose is often the first and best detector. If your tea emits a sour, musty, metallic, or simply “off” aroma that is uncharacteristic of its original scent, consider it a red flag. Fresh tea, whether it’s the delicate floral notes of a white tea or the earthy depth of a black tea, should always have a pleasant, inviting fragrance. Any deviation from this is a strong sign of spoilage.
- Unusual Cloudiness or Sediment: While some teas may naturally develop a slight haze when chilled (this is known as “tea cream” or “tea haze” and is generally harmless), a noticeable murkiness, unusual cloudiness, or the presence of stringy sediment at the bottom of your container, especially if it wasn’t there initially, can indicate bacterial growth or spoilage. This is particularly true if the cloudiness is accompanied by an off-smell.
- Visible Mold Growth: This is the most unequivocal and dangerous sign of spoiled tea. If you spot any fuzzy patches, colored spots (white, green, black, or blue), or slimy films growing on the surface or sides of your container, discard the tea immediately without hesitation. Mold can produce toxins and should never be consumed. It’s important not to try and skim off the mold, as its spores and roots can be invisible and extend throughout the liquid.
When in doubt, always err on the side of caution. The minor inconvenience of brewing a new batch of tea far outweighs the potential health risks associated with consuming expired or contaminated tea.

Creative Ways to Enjoy Tea Nearing Its Expiry
As your brewed tea approaches the end of its recommended shelf life but is still perfectly safe to consume, don’t let it go to waste. Here are a couple of imaginative ways to savor those last delicious drops:
- Host an Impromptu Tea Gathering: If you have a good quantity of tea that’s still fresh but needs to be enjoyed soon, why not gather a few friends for a casual tea party? Serve it as a refreshing iced tea on a warm afternoon or gently rewarm it for a cozy hot tea session. Sharing the joy of tea is a wonderful way to ensure it doesn’t go undrunk.
- Infuse with Fresh Fruit Juices: Give your nearly-expired tea a vibrant new life by mixing it with your favorite fruit juices. A splash of lemon, orange, or berry juice can transform plain tea into a delicious and hydrating beverage. This not only adds a burst of flavor but also provides a healthy, natural way to stay refreshed, especially on a hot summer day. You can also experiment with slices of fresh fruit like cucumber, mint, or ginger for added zest.

Explore More Tea Insights
- The Art Of Tea Tasting
- Apple Ginger Mint Tea Recipe
Conclusion: Savor Every Sip with Smart Storage
By now, you’re equipped with a comprehensive understanding of the varying shelf lives of different tea types, the critical factors influencing freshness, and the best practices for optimal storage. No longer will you dread finding that forgotten pitcher; instead, you’ll confidently brew and store your tea, ensuring every cup is a delightful experience. Armed with this knowledge, you can now brew in style and confidence!
What’s your go-to tea variety? Do you prefer the comforting warmth of a hot brew or the invigorating chill of cold brew? And what are your essential additions to elevate your tea-drinking ritual? We’re eager to hear your thoughts and experiences! Spill the tea in our comment section below!
Remember, by implementing these simple yet effective storage tips, you’re not just preserving a beverage. You’re safeguarding a moment of tranquility, a taste of comfort, and a sip of pure satisfaction. So go forth and brew, my friends, knowing your tea will always be at its freshest.
Happy sipping!
